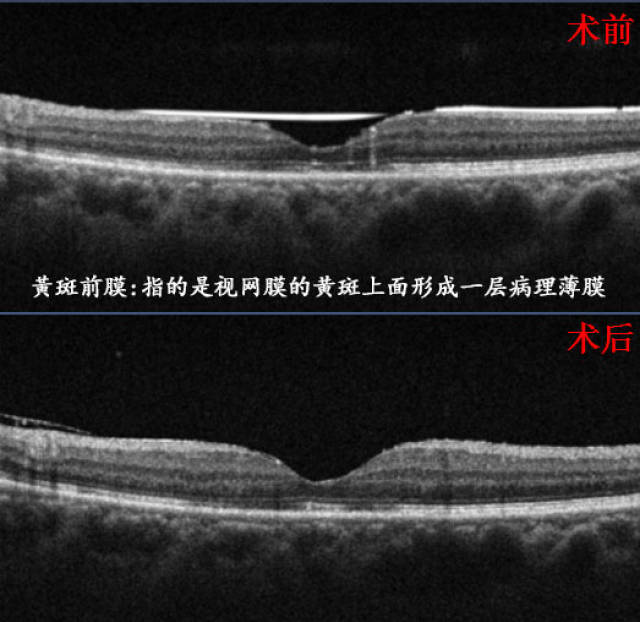
治疗黄斑前膜手术可谓是唯一出路

黄斑前膜

黄斑前膜怎么治疗?
图片尺寸546x608
警惕黄斑前膜
图片尺寸720x859
你见过这样的黄斑前膜吗
图片尺寸1634x1433
黄斑疾病4黄斑前膜
图片尺寸720x719
视力模糊,变形99可能是黄斑前膜6015.
图片尺寸1080x1440关于黄斑前膜治疗的解答
图片尺寸600x534
黄斑前膜的治疗
图片尺寸600x450
黄斑前膜图片
图片尺寸868x603
治疗黄斑前膜手术可谓是唯一出路
图片尺寸523x508
全国爱眼日 | 从甘肃兰州到广东佛山,不远万里除前膜_黄斑
图片尺寸778x398黄斑前膜
图片尺寸640x617黄斑前膜术后为何视网膜脉络膜大面积萎缩有4点关键原因
图片尺寸1032x709黄斑前膜黄斑区多长了一层膜严重损害视力
图片尺寸1080x513
黄斑前膜是什么需要治疗吗
图片尺寸552x323
bmc子刊:40岁以下黄斑视网膜前膜患者的临床研究_黄斑视网膜前膜_医脉
图片尺寸693x801
变性,特发性息肉状脉络膜血管病变,玻璃体黄斑牵拉综合征,黄斑前膜
图片尺寸1080x1029
一张图教你自测黄斑前膜
图片尺寸1080x1104
警惕黄斑前膜
图片尺寸1920x2043
oct可见:黄斑前膜 轻水肿
图片尺寸800x377
黄斑前膜
图片尺寸977x741
猜你喜欢:黄斑前膜oct图像黄斑前膜图片黄斑裂孔oct图像黄斑结构睑黄瘤术后睑黄瘤是什么引起的视网膜脱离的眼底图片睑黄瘤的最佳治疗方法眼睑脂肪粒睑黄瘤图片 治疗方法眼睛角膜炎图片黄斑水肿 oct睑黄疣是怎么引起的年轻人眼睑黄瘤图片毛囊炎鸡皮肤脂肪粒皮肤睑黄瘤 治疗方法眼睛眼皮长睑黄瘤图片结膜炎长什么样图片眼睑黄斑瘤怎么去除黄斑oct眼睑黄瘤眼睑汗管瘤角膜白斑初期照片眼睑黄斑瘤自己掉了眼睑黄斑瘤正常黄斑图片眼皮上长黄斑瘤图片黄斑oct的正常图解黄斑前膜oct牛大碗拉面吧台桌图片荷叶荷花高清图片夏季马丁靴女奥康女凉鞋2021年新款车标是b的奔驰张瑞萱青蛙怎么画动物几何形体素描 静物男童眉毛画法鱼丁糸followmecharan图片爱人